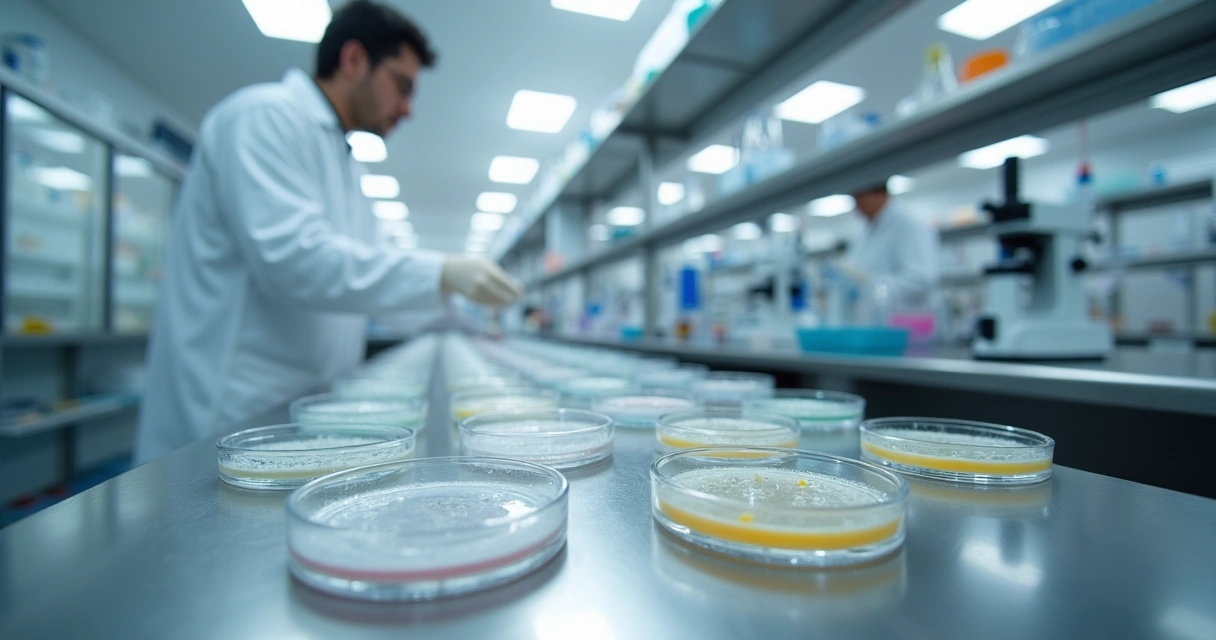
Técnico analisando amostras em laboratório de microbiologia

Em muitos anos acompanhando a rotina de indústrias e fábricas de alimentos, percebi uma coisa: um checklist de análise microbiológica bem pensado reduz riscos e evita muita dor de cabeça. Eu já vi situações onde um simples item não verificado gerou prejuízos enormes. Por isso quero mostrar, de forma didática, como montar o seu checklist, apontando cada item que não pode faltar. Vou contar também um pouco das minhas experiências e mostrar como plataformas como o Food Platform ajudam a trazer mais segurança, controle e resultado.
Por que a análise microbiológica é tão relevante?
Antes de apontar os itens do checklist, preciso dividir uma verdade que poucos falam: os microrganismos são invisíveis, mas as consequências da falta de controle deles são bem visíveis em número de reclamações, perdas e auditorias reprovadas. Tive contato com casos de empresas que achavam desnecessário tanto rigor, até aparecer uma contaminação ou um surto de doenças alimentares.
Hoje, toda indústria de alimentos que opera conforme as normas sabe que os perigos microbiológicos são uma ameaça ao consumidor, à reputação da fábrica e à continuidade das vendas. Alguns microrganismos patogênicos exigem apenas pequenas falhas para multiplicar-se rapidamente e comprometer tudo.
Principais perigos microbiológicos em alimentos
Durante a elaboração do seu checklist de análise microbiológica, é preciso considerar os perigos que realmente afetam o tipo de produto fabricado. Entre os mais comuns, sempre destaco:
- Bactérias patogênicas (Salmonella, Listeria, E. coli, Staphylococcus aureus)
- Fungos e leveduras (por crescimento ou produção de toxinas)
- Vírus (principalmente norovírus e hepatite A)
- Parasitas (Giardia, Toxoplasma, entre outros)
Os riscos e microrganismos mudam conforme matéria-prima, processo, ambiente e tipo de produto, então o checklist precisa ser desenhado com base nisso.
Normas que regulam a análise microbiológica
Eu recomendo sempre começar conhecendo normas e legislações aplicáveis. No Brasil, a Anvisa, o Ministério da Agricultura e órgãos estaduais exigem controles rígidos. Entre as principais normas estão:
- RDC 275 (Boas Práticas de Fabricação)
- Instrução Normativa 60/2019 (Padrões microbiológicos de alimentos)
- Manuais de APPCC, ISO 22000 e FSSC 22000
Sem seguir essas normas, todo o trabalho de monitoramento pode ser desconsiderado numa auditoria. E foi nessas horas que vi o Food Platform brilhar, porque ele mantém tudo registrado, facilitando rastreio e apresentação de documentos.
Checklist não é papelada. É segurança, credibilidade e proteção de vidas.
Primeiros passos para montar seu checklist
O começo exige conhecimento detalhado dos processos da sua indústria. Eu recomendo mapear cada etapa produtiva, desde a chegada da matéria-prima até a expedição. O Food Platform, por sinal, automatiza esse mapeamento, trabalhando junto aos setores para garantir que nenhum ponto de controle se perca.
Como identificar pontos críticos de controle?
Para saber onde os riscos microbiológicos são maiores, observe:
- Itens de contato direto com o alimento
- Locais que acumulam resíduos e umidade
- Fases de menor temperatura (exemplo: resfriamento lento)
- Processos abertos ou manuais
- Equipamentos compartilhados entre linhas
Nesse levantamento inicial, costumo envolver líderes das linhas, pessoas da manutenção e do controle de qualidade. Sem essa visão completa, o checklist fica “cego”.
Itens concretos para seu checklist de análise microbiológica
Cada item que vou listar abaixo é fruto de aprendizados reais. Muitas vezes, só percebi a ausência deles quando enfrentei um problema na prática. Sugiro que cada empresa adapte às suas características, mas essas categorias são universais:
1. Check de condições higiênico-sanitárias
Aqui entram itens para garantir que superfícies, equipamentos, utensílios e ambientes estejam aptos para contato com o alimento. Costumo incluir:
- Conferência de limpeza pós-produção e pré-operacional
- Inspeção visual de resíduos e sujidades
- Verificação de presença de pontos de acúmulo de água e resíduos
- Controle de pragas: registros de barreiras físicas e armadilhas
- Checagem de manutenção das instalações
Toda resposta negativa, para mim, deve gerar ação corretiva formalizada. O Food Platform ajuda registrando, acompanhando responsáveis e prazos nesses planos de ação, diferente de alguns concorrentes que param apenas na identificação sem ferramentas integradas de gestão de planos corretivos.
2. Amostragens programadas
O checklist deve prever quando, onde e por quem as amostras microbiológicas serão colhidas.
- Definição de pontos de coleta e periodicidade
- Registro de responsável pela coleta
- Identificação clara de lote e data
- Condições de transporte da amostra ao laboratório
Todo item do checklist tem que garantir que não haja dúvidas sobre origem e rastreabilidade da amostra. Já presenciei casos em que amostras perderam valor porque faltavam registros e etiquetas. Não arrisque!
3. Escolha de parâmetros de análise
Há uma infinidade de análises possíveis. O correto é selecionar, conforme legislação e riscos, quais parâmetros devem ser analisados. Incluo sempre:
- Indicadores de higiene (coliformes totais e E. coli)
- Patógenos específicos para o produto (ex: Salmonella, Listeria)
- Contagem de bolores e leveduras
- Possibilidade de análises para vírus ou parasitas, se pertinente
Ao montar o checklist no Food Platform, consigo configurar e atualizar os parâmetros conforme as necessidades, sem depender de planilhas avulsas como algumas soluções concorrentes.
4. Definição de métodos e laboratórios parceiros
Algo que nunca aceito é escolher laboratórios só pelo preço. O checklist precisa registrar:
- Qual o método oficial usado (por exemplo: Petrifilm, placas CMA, PCR, etc.)
- Se o laboratório é acreditado pelo Inmetro ou órgão competente
- Procedimentos para envio seguro das amostras
- Conferência de certificação dos laudos recebidos
Já testemunhei erros por não seguir o método oficial. E quando há rastreabilidade digital, como no Food Platform, fica fácil consultar históricos para cada item enviado, ao invés de buscar papelada dispersa.
5. Registro e validação dos resultados
Depois das análises, o checklist deve prever:
- Registro imediato dos resultados, com digitalização dos laudos
- Associação dos resultados ao lote produzido e local de coleta
- Validação dupla (por responsável técnico e laboratório)
- Revisão periódica dos padrões de tolerância/admissão
Se um resultado não conforme aparecer, ele precisa gerar ação, bloqueio do lote e comunicação ao setor responsável. Alguns concorrentes permitem apenas subir relatórios, mas com o Food Platform, os resultados alimentam alertas e planos de ação automáticos, conectando setores e evitando liberação errada.
6. Gestão e tratamento de não conformidades
Um checklist completo só é eficiente se tiver desdobramento para quando algo sai fora do padrão.
- Registro formal da não conformidade (e detalhamento do desvio: produto, local, lote, tipo de microrganismo e valor encontrado)
- Bloqueio imediato do lote/processo envolvido
- Plano de ação, prazos e responsáveis designados
- Reanálise e conferência pós-correção
- Comunicação estruturada entre departamentos
Na minha vivência, já vi fábricas gastarem horas ligando para departamentos e buscando planilhas. Com Food Platform, esse fluxo é automático e integrado. E, sinceramente, isso faz toda a diferença na correria do dia a dia.
Checklist para diferentes tipos de alimentos
Não adianta montar um checklist único para todos os tipos de alimentos. O segredo é conhecer o produto e ajustar os itens-chave. Veja alguns exemplos do que costumo adaptar:
Alimentos prontos para consumo
- Análise periódica de Listeria monocytogenes
- Check de higiene pós-processamento (inclusive EPIs dos funcionários)
- Rastreamento reforçado dos lotes
Esses alimentos, por não passarem por cozimento posterior, exigem rigor máximo. O Food Platform ajuda a manter a rastreabilidade viva e ativa.
Laticínios
- Monitoramento de temperatura desde o recebimento do leite até expedição
- Testes para Staphylococcus aureus e contagem total de bactérias
- Verificação regular da limpeza de ordenhadeiras e tanques
Já encontrei problemas sérios em laticínios que negligenciaram a checagem diária de temperatura. Um simples alarme automatizado poderia ter evitado. Com Food Platform, alarmes de temperatura são integrados ao checklist e ao plano de ação.
Carnes e derivados
- Testes frequentes para Salmonella e E. coli
- Inspeção dos pontos frios nas câmaras
- Controle de utensílios e equipamentos entre turnos
Produtos cárneos requerem checklists ajustados à alta carga microbiana natural. É preciso ser detalhista nos registros.
Produtos de panificação
- Acompanhamento da atividade de água na massa e recheios
- Verificação de manipulação dos ingredientes perecíveis
- Checagem regular dos equipamentos de mistura e divisão
Aqui, costumo reforçar a análise para bolores e leveduras, especialmente nos produtos com recheios úmidos.

Como manter e revisar o checklist de análise microbiológica?
Meu conselho: checklist não é estático. Ele deve ser revisado sempre que houver mudanças no processo, novos produtos ou atualização da legislação. No Food Platform, as versões são controladas, armazenadas e têm histórico digital - um diferencial frente a soluções que usam apenas arquivos soltos ou planilhas.
Quando percebo aumento inesperado de não conformidades, costumo reunir equipe multidisciplinar para revisar itens do checklist, ajustando pontos de coleta, frequência de amostragens ou parâmetros analisados.
Dicas práticas sobre revisão
- Estabeleça prazo máximo para revisão geral do checklist (exemplo: a cada 6 meses)
- Avalie indicadores de não conformidade para ajustar focos de controle
- Atualize responsáveis e planos de ação sempre que mudar o fluxo
- Mantenha checklist disponível para todos os envolvidos, sempre na última versão
Tecnologia no acompanhamento do checklist microbiológico
Nos últimos anos, vi o papel perdendo espaço para soluções digitais. Usar tecnologia para monitorar e garantir a execução dos checklists é mudança mais do que bem-vinda.
Minha experiência com o Food Platform mostra algumas vantagens:
- Digitalização de registros, rastreio rápido em auditorias e fiscalizações
- Planos de ação automáticos e comunicação entre setores sem papéis perdidos
- Anexos de evidências fotográficas, laudos e outros comprovantes
- Alertas de vencimentos ou pendências em tempo real
- Indicadores em dashboards com histórico e comparação mensal
Já trabalhei com plataformas nacionais e importadas que entregam parte dessas funcionalidades. O diferencial do Food Platform é a integração de todos os dados, planos de ação e rastreabilidade, facilitando auditorias e tomadas de decisão com segurança.
O check digital transforma a rotina de segurança de alimentos, tornando-a confiável e auditável.
Erros comuns no uso do checklist microbiológico
Ao longo do tempo, percebi que muitos problemas não estão na falta do checklist, mas no seu uso incorreto. São deslizes fáceis de evitar:
1. Respostas “mecânicas”
Marcar itens sem realmente verificar. Eu já vi funcionários preenchendo checklists antes da limpeza, apenas porque era rotina. O acompanhamento digital minimiza isso, pois cada ação pode requerer foto, hora e login de usuário.
2. Não atualização conforme mudanças
Quando processos mudam, ingredientes novos chegam ou equipamentos são trocados, o checklist precisa ser revisado. Já testemunhei problemas porque se esqueceu disso. Com o Food Platform, todo ajuste fica registrado, evitando versões desatualizadas em circulação.
3. Falta de análise crítica
Checklist não pode ser um ritual. Precisa de análise crítica dos resultados e revisão de pontos críticos. O Food Platform ajuda oferecendo dashboards que facilitam enxergar tendências e áreas de atenção.
Como garantir o envolvimento de todos?
Eu acredito que cultura de segurança alimentar se constrói na prática e no dia a dia. Por isso, todo mundo deve entender o motivo de cada item do checklist.
- Promova treinamentos curtos e constantes
- Mostre exemplos reais de riscos e consequências
- Reconheça boas práticas entre os colaboradores
- Abra espaço para sugestões de aprimoramento do checklist
Com a comunicação digital do Food Platform, os treinamentos podem ser registrados, as ações reconhecidas e as sugestões documentadas.

Checklist microbiológico em auditorias e certificações
Já acompanhei várias empresas durante auditorias de certificação. Um bom checklist documentado é um dos fatores que mais gera confiança aos auditores. Nas últimas auditorias que presenciei, tudo ficou mais simples quando a empresa usava o Food Platform para acessar, em segundos, qualquer registro solicitado.
- Auditorias internas e externas exigem rastreabilidade completa
- Certificações como FSSC, BRC e ISO 22000 demandam histórico claro de não conformidades e ações corretivas
Quem usa o Food Platform consegue apresentar esses dados prontos. Outras soluções até cumprem o básico, mas a integração das informações ainda não atinge o mesmo nível de praticidade e confiança.
Checklist e rastreabilidade: porque são inseparáveis
Meu contato próximo com áreas de controle de qualidade mostrou que rastreabilidade vai além de etiquetas. O checklist de análise microbiológica deve registrar todas as relações entre:
- Dados do produto: lote, linha, data, time de produção
- Procedência das matérias-primas
- Parâmetros e resultados de cada análise
- Ações corretivas tomadas
- Destino do produto não conforme
Somente assim é possível agir rapidamente em situações de recall, bloqueio ou investigação de causas. O Food Platform centraliza todas essas informações em um só lugar.
Rastreabilidade rápida evita prejuízo, perda de clientes e crises maiores.
Construindo o seu checklist: passo a passo final
Baseado em tudo que já vi e cometi de erros (e acertos!), minha sugestão para quem está começando é seguir esta ordem:
- Mapear processos, linhas e produtos
- Elaborar o fluxograma de produção
- Identificar pontos críticos e perigos específicos
- Escolher os parâmetros e métodos de análise junto à equipe técnica
- Definir periodicidades e responsáveis por cada coleta
- Registrar tudo digitalmente, de preferência em sistema integrado
- Acompanhar planos de ação e indicadores para revisões futuras
No Food Platform, todas essas etapas são padronizadas e adaptáveis às necessidades da fábrica, trazendo mais segurança e agilidade que qualquer alternativa que conheci até hoje.
Como a tecnologia pode transformar o seu controle microbiológico?
Eu já presenciei fábricas que gastavam dias para reunir dados para uma auditoria, e outras que, com plataformas automatizadas, em menos de uma hora já tinham tudo em mãos. Esse tempo economizado reflete não só produtividade, mas confiança diante dos clientes, órgãos reguladores e auditorias.
- Monitoramento em tempo real dos processos
- Alertas para pendências e desvios
- Histórico seguro e backup automático
- Facilidade de treinamento graças à centralização dos procedimentos
Já testei alternativas no mercado, mas a integração entre setores, o foco nas normas brasileiras e a agilidade de adequação do Food Platform me mostraram que ele entrega não só praticidade, mas a credibilidade que toda indústria deseja.
Conclusão
Eu acredito que um bom checklist de análise microbiológica é o verdadeiro pilar da gestão de segurança de alimentos. Não se trata de burocracia: é garantia de qualidade, saúde e reputação. Quando bem elaborado e digitalizado, ele vira ferramenta de crescimento, atende normas e previne crises silenciosas mas devastadoras.
Se você quer montar, revisar ou automatizar seu checklist, te convido a conhecer o Food Platform. Faça parte do grupo que coloca a segurança à frente, transforma dados em resultados e torna impossível perder o controle dos processos. Confie em quem entende o desafio e entrega soluções adaptadas à realidade brasileira. Chegou o momento de escolher o caminho mais seguro para o seu negócio e para o consumidor final. Teste agora o Food Platform e sinta na prática essa mudança.





